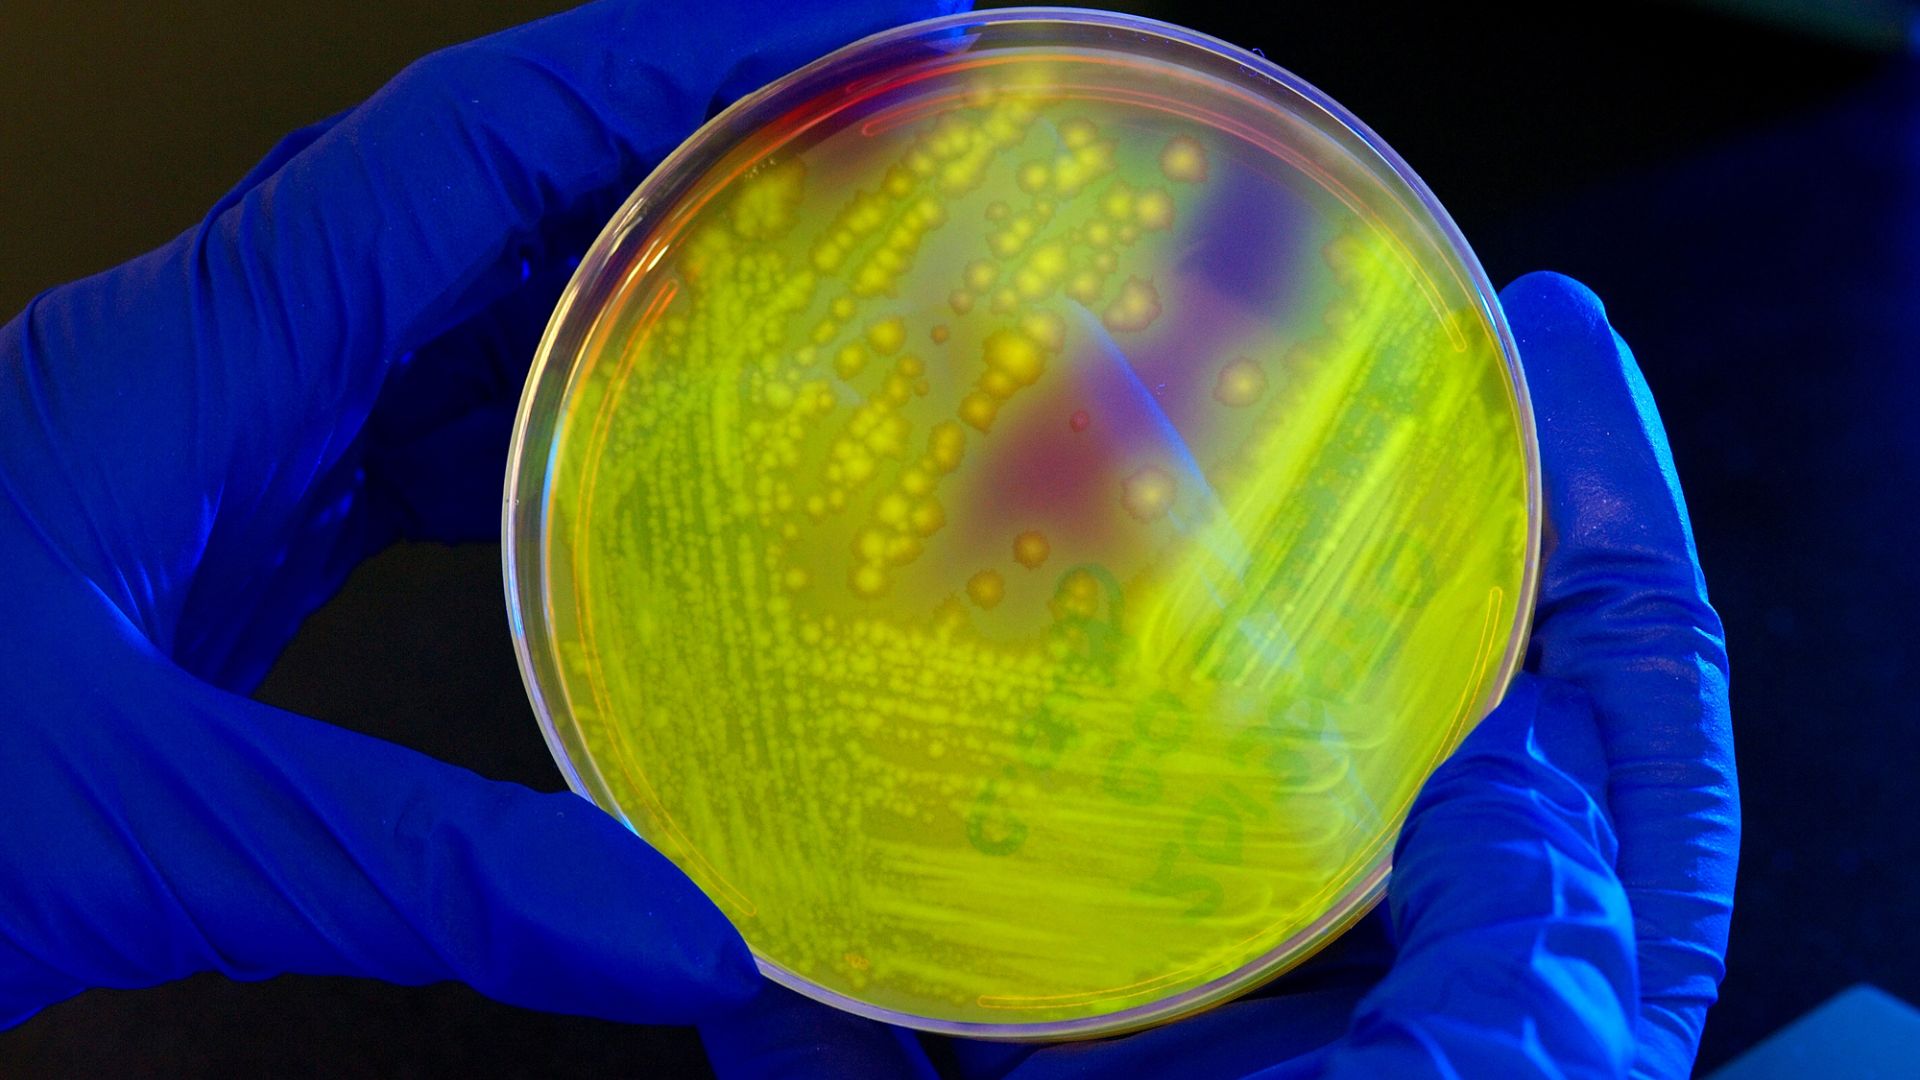

Tìm hiểu chung về chốc lở ở trẻ em
Chốc lở là một bệnh nhiễm trùng da cấp tính do vi khuẩn gây ra tổn thương nằm ở lớp biểu bì nông của da. Đây là một trong những bệnh nhiễm trùng da phổ biến nhất, đặc biệt ở trẻ nhỏ. Chốc lở được đặc trưng bởi các mụn mủ và vết xước đóng vảy màu vàng mật. Mặc dù bệnh có thể ảnh hưởng đến mọi lứa tuổi, nhưng nó phổ biến nhất ở trẻ em trong độ tuổi từ 2 đến 5 tuổi, chiếm khoảng 10% các bệnh về da ở trẻ em.
Có ba dạng chính của chốc lở:
- Chốc lở không bọng nước (Non-bullous impetigo): Đây là dạng phổ biến nhất, chiếm tới 70% các trường hợp nhiễm trùng chốc lở ở cả người lớn và trẻ em. Nó còn được gọi là “chốc lở học đường”.
- Chốc lở bọng nước (Bullous impetigo): Dạng này ít phổ biến hơn và thường gặp ở trẻ sơ sinh và trẻ nhỏ dưới 2 tuổi. Hơn 90% các trường hợp chốc lở bọng nước ảnh hưởng đến trẻ em dưới 2 tuổi.
- Chốc lở loét (Ecthyma): Đây là một dạng sâu hơn và nghiêm trọng hơn của chốc lở, gây ra các vết loét sâu hơn vào lớp hạ bì của da. Chốc lở loét thường là biến chứng của chốc lở không được điều trị.
Triệu chứng thường gặp của chốc lở ở trẻ em
Những triệu chứng của chốc lở ở trẻ em
Các triệu chứng của chốc lở thường phát triển trong vòng ba ngày sau khi vi khuẩn xâm nhập vào da trẻ. Chốc lở có thể gây ngứa, đôi khi đau đớn và bắt đầu bằng các vết loét hoặc mụn nước màu đỏ. Tuy nhiên, trên da sẫm màu, các vết đỏ ban đầu có thể khó nhìn thấy hơn.
- Chốc lở không bọng nước (Non-bullous impetigo): Thường xuất hiện trên mặt (quanh mũi và miệng) và các chi, nhưng có thể xuất hiện ở bất kỳ bộ phận nào của cơ thể. Bắt đầu bằng một nốt ban đỏ đơn lẻ, sau đó phát triển thành mụn mủ hoặc mụn nước. Sau đó, mụn mủ hoặc mụn nước vỡ ra, giải phóng dịch tiết có màu vàng trong, sau đó khô lại và tạo thành vảy màu vàng mật đặc trưng. Các vảy này có thể trông giống như vảy ngô dính trên da. Vùng da xung quanh thường có ít hoặc không có ban đỏ xung quanh.
- Chốc lở bọng nước (Bullous impetigo): Thường xuất hiện trên mặt, thân, các chi, mông và vùng quanh hậu môn. Biểu hiện dưới dạng các bọng nước bề mặt, nhỏ hoặc lớn, có mái mỏng xuất hiện nhanh chóng, có xu hướng tự vỡ và chảy dịch vàng, để lại một viền da tróc vảy (collarette). Thường không có ban đỏ đáng kể quanh vùng da bị ảnh hưởng. Dạng này có thể lây lan xa do tự lây nhiễm.
- Chốc lở loét (Ecthyma): Đây là dạng chốc lở sâu hơn, các tổn thương loét xuyên qua biểu bì và sâu vào lớp hạ bì. Các vết loét xuất hiện như những tổn thương "khoét sâu" với các bờ màu tím. Các vảy có thể có màu vàng mật hoặc nâu đen và có thể có mủ. Sau bệnh thường để lại sẹo vì nhiễm trùng đã đi sâu vào da.

Tác động của chốc lở ở trẻ em với sức khỏe
Chốc lở là một bệnh rất dễ lây lan, do đó, tác động chính là khả năng lây lan nhanh chóng sang các vùng da khác của trẻ (tự lây nhiễm) và sang người khác, đặc biệt là trong môi trường đông người như trường học hoặc nhà trẻ. Nếu không được điều trị, nhiễm trùng có thể lan sâu hơn vào các lớp da hoặc sang các bộ phận khác của cơ thể. Mặc dù thường tự giới hạn và khỏi trong vòng 14 - 21 ngày nếu không điều trị (và khoảng 20% trường hợp tự khỏi), việc điều trị bằng kháng sinh có thể rút ngắn thời gian khỏi bệnh xuống còn khoảng 10 ngày.
Biến chứng có thể gặp khi mắc chốc lở ở trẻ em
Mặc dù hầu hết các trường hợp chốc lở đều cải thiện khi điều trị, nhưng một số biến chứng có thể xảy ra, đặc biệt nếu nhiễm trùng không được điều trị hoặc do các chủng vi khuẩn cụ thể gây ra:
- Nhiễm trùng lan rộng: Nhiễm trùng da ban đầu có thể lan sâu vào mô dưới da, gây ra các tình trạng nghiêm trọng hơn như viêm mô tế bào, viêm mạch bạch huyết hoặc nhiễm khuẩn huyết. Nếu không được điều trị kịp thời, các biến chứng này có thể đe dọa tính mạng.
- Viêm cầu thận cấp sau nhiễm liên cầu: Đây là một biến chứng thận cấp tính hiếm gặp nhưng nghiêm trọng, xảy ra sau nhiễm trùng do Streptococcus pyogenes (liên cầu khuẩn nhóm A). Biến chứng này thường xuất hiện từ 2 đến 6 tuần sau khi nhiễm trùng da. Các triệu chứng bao gồm sốt, tăng huyết áp, phù nề và tiểu ra máu. Trong một số ít trường hợp, có thể dẫn đến suy thận, đặc biệt nếu nhiễm trùng do liên cầu khuẩn.
- Hội chứng da bị bỏng do tụ cầu: Xảy ra khi độc tố do tụ cầu vàng (Staphylococcus aureus) lan tỏa trong cơ thể, gây tổn thương lan rộng ở lớp thượng bì, tạo bong tróc da giống bỏng.
- Sốt ban đỏ: Là biểu hiện toàn thân do độc tố ngoại bào của liên cầu khuẩn nhóm A, đặc trưng bởi phát ban đỏ lan tỏa, kèm theo sốt, đau họng và nổi hạch.
Khi nào cần gặp bác sĩ?
Nếu có dấu hiệu bệnh chốc lở như đã kể trên, các dấu hiệu nhiễm trùng toàn thân, nổi hạch, tổn thương khoang miệng hoặc liên quan đến mô sâu,... bạn nên đến khám bác sĩ ngay để được chẩn đoán và điều trị kịp thời.
Nguyên nhân gây bệnh chốc lở ở trẻ em
Chốc lở ở trẻ em là do nhiễm trùng vi khuẩn, chủ yếu là vi khuẩn gram dương. Các loại vi khuẩn phổ biến nhất gây chốc lở là:
- Staphylococcus aureus: Gây ra 80% các trường hợp chốc lở không bọng nước. Đây cũng là nguyên nhân gần như độc quyền của chốc lở bọng nước.
- Streptococcus pyogenes (liên cầu khuẩn tan huyết nhóm A - GABHS): Streptococcus hay "liên cầu khuẩn" gây ra 10% các trường hợp chốc lở không bọng nước. Trong 10% các trường hợp còn lại, nguyên nhân là sự kết hợp của cả S. aureus và GABHS.
Vi khuẩn thường xâm nhập vào da trẻ thông qua các vết đứt, trầy xước, phát ban hoặc vết côn trùng cắn, làm tổn thương hàng rào bảo vệ da.
- Chốc lở nguyên phát: Xảy ra trên da trước đó bình thường bị xâm nhập trực tiếp bởi vi khuẩn.
- Chốc lở thứ phát: Xảy ra khi nhiễm trùng hình thành tại một vị trí vết thương da trước đó.
Nguy cơ mắc phải chốc lở ở trẻ em
Những ai có nguy cơ mắc phải chốc lở ở trẻ em?
Chốc lở phổ biến nhất ở trẻ nhỏ, đặc biệt là trẻ từ 2 đến 5 tuổi. Trẻ sơ sinh đặc biệt dễ mắc chốc lở bọng nước, với hơn 90% trường hợp xảy ra ở trẻ dưới 2 tuổi. Ngoài ra, một số đối tượng khác cũng có nguy cơ mắc chốc lở cao hơn:
- Trẻ em sống trong môi trường nóng ẩm.
- Những người sống trong môi trường đông đúc như nhà trẻ hoặc các khu dân cư đông đúc.
- Những người có các tình trạng da như viêm da dị ứng, viêm da tiếp xúc, bệnh ghẻ, thủy đậu, chàm hoặc chấy rận.
- Những người có chấn thương da như vết rách, vết côn trùng cắn, bỏng nhiệt, trầy xước, vết cắt hoặc bỏng.
- Những người bị suy giảm miễn dịch chẳng hạn như bệnh nhân đái tháo đường, nhiễm HIV hoặc đang hóa trị ung thư.
- Những người có vệ sinh kém hoặc suy dinh dưỡng.
Yếu tố làm tăng nguy cơ mắc phải chốc lở ở trẻ em
Một số yếu tố có thể làm tăng đáng kể nguy cơ mắc chốc lở ở trẻ em:
- Khí hậu nóng ẩm: Chốc lở phổ biến hơn trong những tháng ấm áp khi trẻ em ra ngoài nhiều hơn, với tỷ lệ mắc bệnh cao nhất vào mùa hè và mùa thu.
- Vệ sinh kém: Vệ sinh không đúng cách là một yếu tố tiền đề cho chốc lở không bọng nước.
- Gãi: Hành vi gãi các vùng da ngứa hoặc bị tổn thương có thể làm lây lan vi khuẩn và tạo ra các vết thương mới cho vi khuẩn xâm nhập.
- Suy giảm miễn dịch: Các tình trạng làm suy yếu hệ miễn dịch như tiểu đường, HIV hoặc hóa trị có thể tăng nguy cơ nhiễm trùng.
- Tiếp xúc với người bệnh: Chốc lở rất dễ lây lan qua tiếp xúc trực tiếp hoặc dùng chung đồ dùng cá nhân với người nhiễm bệnh.
Phương pháp chẩn đoán và điều trị chốc lở ở trẻ em
Phương pháp xét nghiệm và chẩn đoán chốc lở ở trẻ em
Việc chẩn đoán chốc lở ở trẻ em chủ yếu dựa vào việc khám lâm sàng và các biểu hiện triệu chứng. Bác sĩ sẽ kiểm tra các vết loét trên mặt hoặc cơ thể của trẻ. Thông thường, không cần xét nghiệm trong phòng thí nghiệm để chẩn đoán. Tuy nhiên, trong một số trường hợp, các xét nghiệm có thể cần thiết:
Nuôi cấy và kháng sinh đồ: Lấy mẫu dịch tiết từ vết loét để nuôi cấy và xác định độ nhạy với kháng sinh có thể hữu ích nếu chốc lở tái phát, lan rộng hoặc có lo ngại về nhiễm trùng Staphylococcus aureus kháng methicillin (MRSA) giúp bác sĩ xác định loại kháng sinh phù hợp nhất. Nếu các vết loét không khỏi sau điều trị kháng sinh, xét nghiệm này cũng cần được thực hiện.
Phết mũi: Trong trường hợp nhiễm trùng tái phát, phết mũi nên được thực hiện để xác định sự mang vi khuẩn tụ cầu trong mũi để có kế hoạch quản lý bệnh cụ thể.
Sinh thiết da: Hiếm khi được chỉ định nếu chẩn đoán không rõ ràng (đặc biệt đối với chốc lở bọng nước) hoặc nếu bệnh không đáp ứng với điều trị.
Xét nghiệm HIV: Nên được xem xét khi một người lớn khỏe mạnh trước đây phát triển chốc lở bọng nước, do những người có hệ miễn dịch suy yếu dễ mắc chốc lở hơn.
Phương pháp điều trị chốc lở ở trẻ em
Điều trị chốc lở bao gồm việc sử dụng kháng sinh bôi ngoài da đơn thuần hoặc kết hợp với kháng sinh đường uống.
Nội khoa
Kháng sinh: Kháng sinh đường uống được khuyến nghị trong tất cả các trường hợp chốc lở bọng nước, các trường hợp chốc lở không bọng nước lan rộng (hơn 3 hoặc 5 tổn thương), khi điều trị tại chỗ thất bại hoặc khi trẻ có nguy cơ cao bị biến chứng hoặc khi trẻ có triệu chứng toàn thân. Các kháng sinh kháng beta-lactamase như cephalexin, amoxicillin-clavulanate, dicloxacillin là lựa chọn hàng đầu. Flucloxacillin đường uống cũng thường là lựa chọn đầu tay. Cefadroxil đường uống đã được sử dụng thành công trong một trường hợp chốc lở không bọng nước lan rộng trên mặt. Ở những khu vực có tỷ lệ MRSA cao hoặc nếu kết quả nuôi cấy dương tính với MRSA, clindamycin hoặc doxycycline là các phương pháp điều trị được ưu tiên. Điều cần thiết là phải hoàn thành toàn bộ liệu trình kháng sinh, ngay cả khi các vết loét đã lành, để đảm bảo loại bỏ hoàn toàn nhiễm trùng và ngăn ngừa tái phát.
Nhập viện: Trong những trường hợp nặng, khi vùng bị ảnh hưởng rộng lớn hoặc có nhiều tiêu chí cần dùng kháng sinh đường uống, có thể cần nhập viện và dùng kháng sinh đường tĩnh mạch.
Thuốc không kê đơn: Đối với các nhiễm trùng nhỏ chưa lan rộng, có thể thử điều trị bằng kem hoặc thuốc mỡ kháng sinh không kê đơn có chứa bacitracin, sau đó phủ một băng không dính lên vùng đó để ngăn nhiễm trùng lây lan.
Thuốc sát trùng: Các loại kem sát trùng như kem hydrogen peroxide 1% hoặc thuốc mỡ povidone-iodine 10% được khuyến nghị bôi 2-3 lần mỗi ngày trong 5-7 ngày.

Ngoại khoa
Chưa ghi nhận các biện pháp điều trị ngoại khoa cho bệnh chốc lở.
Chế độ sinh hoạt và phòng ngừa chốc lở ở trẻ em
Những thói quen sinh hoạt có thể giúp bạn hạn chế diễn nặng của chốc lở ở trẻ em
Bên cạnh việc điều trị y tế, các thói quen sinh hoạt và vệ sinh hàng ngày đóng vai trò quan trọng trong việc hạn chế sự diễn biến nặng và ngăn ngừa lây lan của chốc lở.
Chế độ dinh dưỡng
Việc duy trì một chế độ dinh dưỡng đầy đủ và cân bằng là quan trọng để hỗ trợ hệ miễn dịch khỏe mạnh, giúp cơ thể chống lại nhiễm trùng hiệu quả hơn và có thể gián tiếp giúp hạn chế diễn biến của bệnh.
Chế độ sinh hoạt
Giữ vết loét được che phủ: Băng bó các vết loét hoặc mặc quần áo dài tay và chân để ngăn chặn sự lây lan vi khuẩn sang các vùng khác của cơ thể hoặc sang người khác.
Vệ sinh tay tốt: Rửa tay thường xuyên bằng xà phòng và nước, đặc biệt là trước và sau khi bôi kem kháng sinh và sau khi chạm vào vết phát ban.
Tránh chạm hoặc gãi: Tuyệt đối không chạm hoặc gãi các vết loét, mụn nước hoặc vùng da đóng vảy. Hành động này không chỉ giúp ngăn ngừa lây lan mà còn giảm nguy cơ để lại sẹo.
Tránh dùng chung đồ dùng: Không dùng chung khăn mặt, khăn tắm, ga trải giường, gối, đồ dùng cá nhân hoặc dụng cụ thể thao với người khác.
Tránh tiếp xúc gần: Không nên tiếp xúc gần với những người khác, đặc biệt là những người mắc bệnh tiểu đường hoặc có hệ miễn dịch suy yếu.

Phương pháp phòng ngừa chốc lở ở trẻ em hiệu quả
Một số phương pháp phòng ngừa bệnh hiệu quả:
- Rửa tay thường xuyên: Trẻ em cần rửa tay kỹ bằng xà phòng và nước nhiều lần trong ngày, đặc biệt là trước khi ăn, sau khi đi vệ sinh và sau khi chạm vào vết loét hoặc băng gạc. Sử dụng nước rửa tay chứa cồn nếu không có xà phòng và nước.
- Cắt móng tay ngắn: Giúp ngăn ngừa việc gãi gây tổn thương da và lây lan vi khuẩn.
- Tắm rửa hàng ngày: Tắm rửa thường xuyên (hoặc càng thường xuyên càng tốt) bằng xà phòng, đặc biệt quan trọng đối với trẻ có chàm hoặc da nhạy cảm.
- Làm sạch vết thương: Lau sạch ngay lập tức các vết cắt, trầy xước, vết côn trùng cắn hoặc bất kỳ tổn thương da nào khác bằng xà phòng và nước ấm.
- Bôi kem kháng sinh: Sau khi làm sạch, bôi kem hoặc thuốc mỡ kháng sinh không kê đơn lên vết thương và băng lại bằng băng không dính.